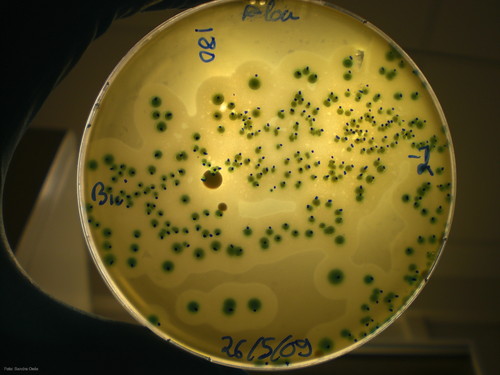

Investigadores castellano leoneses han analizado la presencia de agentes patógenos en alimentos decomisados en las fronteras europeas.
Las enfermedades transmitidas por los alimentos, como la salmonella o la listeria, son una amenaza para la salud pública a nivel mundial debido a su alta prevalencia y a los costes asociados a su tratamiento. Se estima que hasta un 30 por ciento de la población que vive en los países industrializados sufre alguna enfermedad transmitida por los alimentos cada año y que el coste sanitario asociado, en el caso de Estados Unidos, se acerca a los 77.700 millones de dólares anuales.
En el marco del proyecto del VII Programa Marco de la Unión Europea Promise-NET, investigadores del Instituto Tecnológico Agrario de Castilla y León (Itacyl), la Universidad de Burgos, la Universidad de Medicina Veterinaria de Viena (Austria), el Federal Institute for Risk Assessment de Alemania, el Complejo Asistencial Universitario de León y el Instituto de Biomedicina (Ibiomed) de la Universidad de León han analizado la presencia de agentes patógenos en alimentos decomisados en las fronteras europeas.
Uno de los trabajos enmarcados en este proyecto se ha centrado en estudiar los alimentos de origen animal confiscados a los pasajeros de vuelos procedentes de fuera de la Unión Europea en el aeropuerto internacional de Bilbao, entre abril de 2012 y junio de 2013. Los resultados de este estudio se han publicado en la revista científica ‘International Journal of Food Microbiology’.
Como detallan los investigadores encabezados por David Rodríguez Lázaro, las pruebas se han centrado en los cuatro principales agentes patógenos notificados con mayor frecuencia en la UE: Campylobacter, Salmonella spp., Escherichia coli enterohemorrágica (ECVT) y Listeria monocytogenes. De un total de 200 muestras de alimentos de origen animal decomisados, 20 fueron positivas para Listeria monocytogenes (el 10 por ciento de total) y 11 para Salmonella spp. (5’5 por ciento), mientras que no se detectó Campylobacter spp. y E. coli en ninguna muestra.
El equipo de científicos también analizó la resistencia a antibióticos por parte de estas bacterias positivas (Listeria monocytogenes y Salmonella spp.) y comprobó que fue alta, especialmente para clindamicina y daptomicina (más del 95 por ciento de los aislamientos). “Estos resultados indican que las muestras de alimentos importados por los viajeros en sus equipajes personales pueden albergar los genotipos más prevalentes de L. monocytogenes genotipos y los serotipos de Salmonella spp, responsables de brotes de origen alimentario en todo el mundo”, aseguran.
Así, los viajes internacionales “pueden jugar un papel importante en la prevalencia y la difusión de clones exitosos de bacterias patógenas transmitidas por los alimentos”, de modo que el monitoreo continuo de los movimientos internacionales “es de importancia para comprender mejor la evolución clonal y la aparición y difusión de los linajes de éxito”.
Los investigadores recuerdan que la fuente potencial de agentes patógenos transmitidos por alimentos es cada vez mayor, ya que existen canales “olvidados” de transmisión (por ejemplo, rutas transfronterizas). Estos productos peligrosos pueden enviarse también por correo o llevarse en el equipaje en forma de partidas personales que contengan carne, leche o productos derivados. Como resultado, la comercialización de alimentos no autorizados que no ha pasado los controles adecuados “constituye una ruta descuidada de transmisión de patógenos de origen alimentario”.
Promise-NET
El proyecto Promise-NET tiene una duración de tres años, entre 2012 y 2014, y un presupuesto global de tres millones de euros. Tiene entre sus fines evaluar las amenazas comunes de seguridad alimentaria y proteger a los consumidores europeos. El proyecto tiene la peculiaridad de englobar a seis países miembros tradicionales de la Unión Europea (Austria, Alemania, Reino Unido, Gracia, Irlanda y España), a otros seis de reciente incorporación (Eslovenia, República Checa, Eslovaquia, Rumanía, Croacia y Hungría) y a otros candidatos que prevén integrarse en un futuro más o menos cercano (como Turquía). El único socio español es la Universidad de Burgos.
Referencia bibliográfica:
Rodríguez-Lázaro, D., Ariza-Miguel, J., Valcarce, M. D., Stessl, B., Beutlich, J., Fernández-Natal, I., ... y Rovira, J. (2014). “Identification and molecular characterization of pathogenic bacteria in foods confiscated from non-EU flights passengers at one Spanish Airport”. International Journal of Food Microbiology.
Fuente: Cristina G. Pedraz/DICYT, http://www.dicyt.com

No hay comentarios aún.